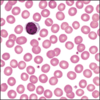
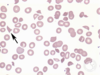
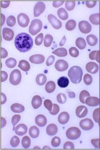

Anemia - KMS Flashcards
(78 cards)
What is anemia? What is it not?
What it is:
a decrease in blood red cell mass or hemoglobin which results in a decreased oxygen-carrying capacity - a symptom
What it isn’t:
a disease, syndrome, or specific diagnosis
How is anemia defined?
Anemia is a laboratory measurement indicating the red cell mass measurement (Hgb or Hct) in a patient is:
determined by each testing laboratory based on:
ØAge and sex
ØAnalytical technique used by testing laboratory
ØGeographic factors such as location (altitude)
When thinking of how anemia is defined in a graph, what should you think of?
Something like this:

What are some of the main symptoms of anemia?
Fatigue
pallor - especially of conjunctiva and palmar creases
What are the symptoms of severe anemia?
Fainting
chest pain
angina
heart attack
How can anemia affect the eyes?
causes yellowing, and pale conjunctiva
How can anemia affect the skin?
Causes paleness, coldness and yellowing
How can anemia affect the respiratory system?
Causes shortness of breath
How can anemia affect the muscular system?
weakness
How can anemia affect the intestinal/GI system?
changed stool color
How can anemia affect the CNS?
Causes fatigue, dizziness, fainting if severe
How can anemia affect the blood vessels?
low blood pressure
How can anemia affect the heart?
palpitations
rapid heart rate
chest pain, angina, heart attack if severe
How can anemia affect the spleen?
enlargement
What are 3 reasons to be anemic?
Blood loss
increased destruction (hemolysis)
decreased RBC production
What are the mechanisms behind blood loss causing anemia?
acute and chronic (kind of a gimme card)
What are some specific examples of acute and chronic blood loss?
Acute: trauma
chronic: GI tract lesions, gynecological disturbances
Increased red cell destruction causing anemia can be the result of what general mechanisms?
Inherited genetic defects
acquired genetic defects
antibody-mediated destruction
microangiopathic hemolytic anemias
infections of red cells
toxic or chemical injury
membrane lipid anomalies
sequestration
Anemia can be caused by hemolysis from inherited genetic defects. What are some examples of these, and the specific disorders that cause them?
Red cell membrane disorders - ie Hereditary spherocytosis, hereditary elliptocytosis
Enzyme deficiencies
Hexose monophosphate enzyme deficiencies - ie G6PD deficiency, glutathione synthetase deficiency
Glycolytic enzyme deficiencies - ie Pyruvate kinase deficiency, hexokinase deficiency
Hemoglobin abnormalities
Deficient globin synthesis - thalassemia syndromes
Structurally abnormal globins (Hemoglobinopathies) - sickle cell disease, unstable Hbs
Acquired genetic defects can also cause anemia through hemolysis. What is a specific mechanism and disease here?
Deficiency of phosphatidylinositol-linked glycoproteins
- Paroxysmal nocturnal hemoglobinuria
Ab mediated destruction is a cause of hemolysis resulting in anemia. What are some specific examples?
Hemolytic disease of the newborn (Rh disease), transfusion reactions, drug-induced, autoimmune disorders
Microangiopathic hemolytic anemias can cause anemia via hemolysis. What are some mechanisms and specific examples?
Hemolytic uremic syndrome, disseminated intravascular coagulation, thrombotic thrombocytopenia purpura
Cardiac traumatic hemolysis - via defective cardiac valves
Repetitive physical trauma - via bongo drumming, marathon running, karate chopping
What infections can cause increased hemolysis, resulting in anemia?
malaria, babesiosis